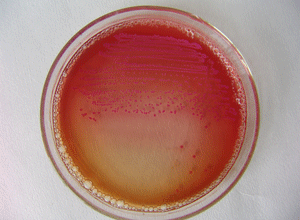
预防性使用抗生素能降低尿动力学检查后泌尿道感染的风险吗？（Cochrane Database Syst Rev. 2012 Oct 17）

-
预防性使用抗生素能降低尿动力学检查后泌尿道感染的…
环球医学资讯
2012年11月12日
点击量:510
1小时0条评论题目:预防性使用抗生素以降低尿动力学检查后泌尿道感染风险(Prophylactic antibiotics to reduce the risk of urinary tract infections after urodynamic studies.) 背景:接受侵入性尿动力学检查(膀胱测压...
-
特殊人群沉默疾病——丙肝的治疗您关注过吗?
环球医学资讯
2012年12月05日
点击量:295
1小时0条评论人们都知道病从口入,但实际上病从血入的危害也很严重。丙型肝炎就是主要通过输血或使用血制品引起的感染。据不完全统计,丙型肝炎病毒(HCV)呈全球性流行,全世界的感染者约有1.7~2亿,我国约有3700万。去年美...
-
终身饮酒影响丙型肝炎患者的治疗结局吗?(Hepatolo…
环球医学资讯
2012年12月05日
点击量:380
1小时0条评论题目:终身饮酒对加入综合医疗保健计划的丙型肝炎患者治疗结局的影响 (The impact of lifetime alcohol use on hepatitis C treatment outcomes in privately insured members of an integrated health care pla...
-
抗生素持续和延时输注的全国调查(Am J Health Syst…
环球医学资讯
2012年11月27日
点击量:358
1小时0条评论题目:抗生素持续和延时输注的全国调查(National survey on continuous and extended infusions of antibiotics.) 目的:为评估beta;-内酰胺类和万古霉素持续和延时输注进行了一项全国性调查。 方法:本调查...
-
革兰阴性菌对氟喹诺酮类药物的敏感性下降(Am J Hea…
环球医学资讯
2012年11月27日
点击量:437
1小时0条评论题目:革兰阴性菌对氟喹诺酮类药物的敏感性下降:对药代动力学、药效学和临床结局的影响(Declining susceptibilities of gram-negative bacteria to the fluoroquinolones:Effects on pharmacokinetics, pharma...
-
合成胶体类或晶体类逆转休克时间相似(Crit Care Me…
环球医学资讯
2012年10月19日
点击量:337
1小时0条评论题目:合成胶体或单用晶体的流体复苏对严重败血症患者的休克逆转、体液平衡和患者结局的作用:一项前瞻性序贯分析(Effects of fluid resuscitation with synthetic colloids or crystalloids alone on shock rev...
-
肺结核:利福喷丁vs.利福平(J Infect Dis. 2012 Oc…
环球医学资讯
2012年10月10日
点击量:667
1小时0条评论题目:在肺结核的强化治疗阶段用利福喷丁代替利福平治疗:肺结核试验协会的研究29(Substitution of Rifapentine for Rifampin During Intensive Phase Treatment of Pulmonary Tuberculosis Study 29 of the Tub...
-
丙型肝炎患者第二次接受干扰素(IFN)治疗的疗效如…
环球医学资讯
2012年10月09日
点击量:312
1小时0条评论题目:已经接受过治疗的丙型肝炎患者干扰素应答没有发生改变:对药物开发和临床决策的影响(Interferon Responsiveness Does Not Change in Treatment-Experienced Hepatitis C Subjects: Implications for Drug ...
-
罗红霉素导致的中毒性表皮坏死松解症(Ther Drug Mo…
环球医学资讯
2012年08月28日
点击量:644
1小时0条评论题目:罗红霉素导致的中毒性表皮坏死松解症(Roxithromycin-induced toxic epidermal necrolysis) 该案例报道了一例非常罕见的药物不良反应,即由于口服罗红霉素而导致的中毒性表皮坏死松解症(TEN)。一位54岁...
-
经验性应用莫西沙星联合美罗培南不会降低重症脓毒症…
环球医学资讯
2012年08月15日
点击量:665
1小时0条评论题目:经验性应用莫西沙星联合美罗培南和单用美罗培南在治疗严重败血症患者脓毒症相关器官功能障碍中的疗效比较:一项随机实验(Effect of empirical treatment with moxifloxacin and meropenem vs meropenem on...

会员登录


网友评论
Yvette05-22
脱发一直是很多人的困扰,希望能广泛应用。
Ada305-22
补碘知识非常全面,获益匪浅。
penelope05-22
“盐重”问题确实需要重视